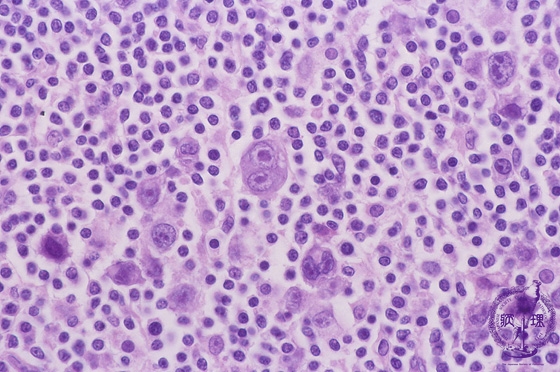
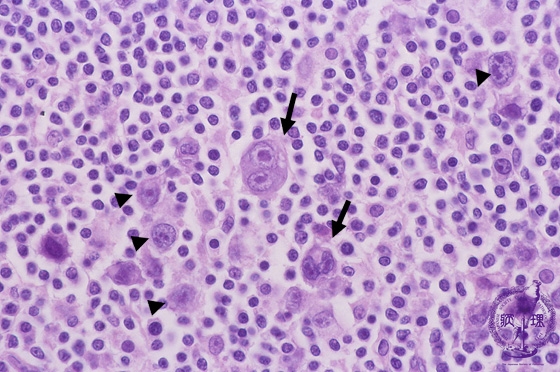
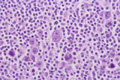

- 2.Lymph node
- ★(4) Hodgkin lymphoma (Nodular sclerosis, mixed cellularity)
Microscopic image (H&E high power view): Hodgkin (arrow head) and Reed Sternberg (arrow) cells have nuclei several times larger than those of typical mature lymphocyte nuclei and contain large reddish brown nucleoli. When compared to background non-tumoral lymphocytes, Hodgkin cells have extremely large nuclei. In these lesions abundant cytokines are produced in abundance, leading to an abnormal immune response. Consequently, there is a prominent background mixed inflammatory response including non-tumoral eosinophils and plasma cells.
Click the image to see the enlarged image.